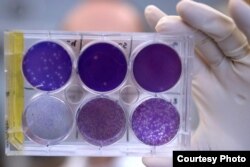
A researcher holds a tray of Zika virus growing in animal cells at Washington University School of Medicine in St. Louis, Missouri. Researchers have identified a human antibody that prevents, in pregnant mice, the fetus from becoming infected and the placenta from being damaged. The antibody also protects adult mice from Zika disease. (Photo courtesy of Huy Mach)

In a potential breakthrough in the fight against Zika, researchers have discovered an antibody that could potentially be fashioned into a vaccine to protect pregnant women against the mosquito-borne virus.
Called ZIKV-117, the antibody — or immune system protein — was isolated from a patient who had been infected with Zika virus.
In a study of pregnant mice infected with the mosquito-borne pathogen, ZIKV-117 protected the fetus against infection. The antibody, which stimulates a robust immune system response against the virus, neutralized all Zika strains that were tested. The amount of virus in the mother was greatly reduced, decreasing levels of the pathogen found in fetal placental and brain tissue.
Infected male mice given a single dose of ZIKV-117 were more likely to survive than untreated mice, even five days after Zika infection, suggesting that the antibody could be used to treat an active infection.
The discovery was made by researchers at Washington University School of Medicine in Missouri and Vanderbilt University in Tennessee, and reported in the journal Nature.
A first against Zika
It is the first time any sort of treatment for Zika has been found, according to Michael Diamond, a microbiologist and immunologist at Washington University, and a senior co-author of the study.
"Before this study, there had been no vaccine or any other study that had done anything in pregnant animals to show that anything could abort or prevent disease,” he said. “So one thing this does is suggest that antibodies are able to do it, and this actually bodes well for future vaccine efforts."
Researchers screened 29 anti-Zika antibodies from five people who had recovered from Zika. ZIKV-117 was identified in one individual with a mild infection.
"That's how this one antibody came to the top of the cream if you will,” Diamond said. “It came to the top of the glass. It turned out to be the best one for inhibiting the virus in cell culture, and then we tested it to see what it could do to Zika virus infection using an animal model — in this case, a mouse model of disease.”
ZIKV-117 proved to be effective in the lab at neutralizing five different strains from around the world.
Global reach
The virus is sweeping through the Americas, from Brazil to Central America, and cases have been reported in the United States. There have also been cases of Zika in Africa, Asia and the Pacific region, prompting public health officials to worry that the emerging disease could become a global threat.
Zika can cause severe birth defects, most notably microcephaly, in the babies of women who are infected with the virus during pregnancy. Newborns with microcephaly have an abnormally small head and brain.
Zika is also thought to cause a rare, crippling neurological condition in adults called Guillain-Barre syndrome.
Diamond said researchers are now preparing to test the antibody in monkeys, a process that he says could take six to nine months. If those experiments are successful, human trials could begin soon after that.
Diamond said ZIKV-117 could be developed into a drug that could be used in a number of ways.
"Either you give it before somebody went into a high-risk area if they were traveling, or as soon as they knew they were pregnant and they were not infected already,” he said. “Or if they were pregnant and then got infected but it was early in their stage of infection, you might be able to administer it and still have beneficial effects."
Because Zika can be transmitted sexually, ZIKV-117 might also be given to infected males to prevent the virus’ spread to their partners. Researchers are also looking to see whether the antibody can treat longstanding infections.
However, Diamond said there's early evidence that Zika may cause sterility in men. Research shows the infection can linger in the eyes and testes.